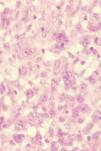

El segundo grupo más frecuente de linfomas cutáneos de células T son los síndromes linfoproliferativos (SLP) CD30+, por detrás del grupo de la micosis fungoide (MF) y sus variantes. Estos engloban la papulosis linfomatoide y los linfomas anaplásicos de células grandes CD30+, polos de un espectro que dejan en su zona central casos intermedios, donde no se puede establecer con seguridad un diagnóstico en base a criterios clínicos e histopatológicos.
Los SLP CD30+ deben diferenciarse de otros procesos linfoproliferativos que pueden presentar células CD30+ en sus infiltrados tumorales, como la propia MF o la enfermedad de Hodgkin, y también de otras entidades inflamatorias o neoplasias no hematológicas que presenten estas células, como es el caso de la pitiriasis liquenoide y varioliforme aguda o determinados tumores mesenquimales («pseudolinfomas CD30+»).
En general, el pronóstico de estos SLP CD30+ es favorable, lo que les diferencia de sus homólogos sistémicos, de origen ganglionar. Resulta muy importante descartar la presencia de linfoma de origen sistémico con afectación extraganglionar, pues el pronóstico y el tratamiento serán diferentes.
CD30+ lymphoproliferative disorders are the most common group of cutaneous T-cell lymphomas after mycosis fungoides and its subtypes. This group includes lymphomatoid papulosis and CD30+ anaplastic large-cell lymphoma; these 2 entities are the extremes of a spectrum with numerous intermediate varieties in which it is not possible to establish a clear diagnosis based on clinical and histopathologic criteria. CD30+ lymphoproliferative disorders must be differentiated from other lymphoproliferative diseases with CD30+ cells in the tumor infiltrates, such as mycosis fungoides or Hodgkin disease, and also from other inflammatory conditions or nonhematological neoplasms that can include this cell type, such as pityriasis lichenoides et varioliformis acuta or certain mesenchymal tumors (CD30+ pseudolymphomas). In contrast to their systemic homologues, which arise in the lymph nodes, CD30+ lymphoproliferative disorders generally have a good prognosis. It is very important to exclude the presence of a lymphoma of systemic origin with extralymphatic spread, as the prognosis and treatment are different.
Con este artículo se pretende hacer una pequeña revisión de los síndromes linfoproliferativos (SLP) CD30+ cutáneos primarios, desde algunos conceptos básicos a novedades terapéuticas y diagnósticas. Se comentan algunas controversias en este campo.
CD30+ (Ki-1)El antígeno CD30 es una proteína transmembrana de 120kD que pertenece a la superfamilia de receptores del factor de necrosis tumoral (TNF)1. Con estos comparte su dominio extracelular, mientras que la región citoplasmática y, secundariamente, los mecanismos de transmisión de señales son diferentes. El gen que lo codifica está en el cromosoma 1p36, cercano a otros relacionados con otros miembros de esta familia.
El CD30L es el ligando de este receptor. Es una proteína transmembrana con un dominio extracelular que presenta gran similitud estructural con otras proteínas como TNFα y β o CD40L. El gen que la codifica se encuentra en el cromosoma 9q33.
El CD30 se expresa en linfocitos T y B activados, en las células de Reed-Stenberg y las células Hodgkin (células propias, aunque no patognomónicas, de la enfermedad de Hodgkin); el CD30L se expresa en linfocitos T activados.
En los ganglios linfáticos normales el CD30 se encuentra en una pequeña población de células mononucleares de gran tamaño con nucleolo llamativo (blastos T y B) que se disponen alrededor de los folículos de células B (parafoliculares, parablastos) y en los centros germinales (centroblastos). Pueden observarse células similares en el bazo o el timo. Fuera de estas localizaciones, en tejidos normales, no existen células CD30+.
La unión de CD30L y CD30 promueve fenómenos de activación, proliferación y diferenciación linfocitaria, pero también muerte celular, en función del tipo celular y de la activación concomitante de otros receptores.
En 1982 se sintetizó el anticuerpo monoclonal Ki-12, dirigido inicialmente contra las células de Reed-Stenberg de la enfermedad de Hodgkin, contra su antígeno CD30; en 1985 el Ki-1 permitió identificar el antígeno CD30+ en otras líneas celulares y surgió un nuevo tipo de linfomas no-Hodgkin: linfomas de células grandes anaplásicas Ki-1/CD30 (LACG). Ki-1 no es el único anticuerpo monoclonal frente a CD30; Ber-H2 es otro anticuerpo con afinidad por otra región del CD30. Este último marca no sólo en la membrana celular, sino también de forma moteada el retículo de Golgi, donde es probable que exista una molécula precursora del CD30 de 84kD.
Además de ser el principal marcador de LACG, encontramos expresión de CD30 en aproximadamente un 30% de todos los tipos de linfomas de células T (marcando las células de mayor tamaño) y en centroblastos e inmunoblastos del 15–20% de linfomas de células B1.
Pseudolinfomas CD30+Aunque el CD30 es el marcador característico del espectro de los SLP CD30+, existen algunas entidades inflamatorias y neoplasias no hematológicas donde la cantidad de células CD30+ puede simular un trastorno SLP tipo LACG o papulosis linfomatoide (PL) (tabla 1). Estas situaciones reactivas se denominan “pseudolinfomas CD30+”3. Algunos rasgos diferenciales son:
- 1.
En los pseudolinfomas las células CD30+ son linfocitos pequeños o medianos en escaso número. Aunque existen linfomas CD30+ con linfocitos pequeños/medianos, lo habitual es que sean células anaplásicas de gran tamaño las que infiltran masivamente la dermis.
- 2.
Generalmente no existe reordenamiento monoclonal del receptor de las células T (TCR).
- 3.
No cursan en forma de brotes de lesiones recurrentes (como por ejemplo en la PL).
Pseudolinfomas CD30+
| Trastornos inflamatorios e infecciones | Pitiriasis liquenoides et varioliformis acuta (PLEVA) |
| Dermatitis atópica | |
| Toxicodermias (carbamacepina) | |
| Síndrome de recuperación linfocitaria | |
| Infecciones virales (herpesvirus en pacientes inmunodeprimidos, molluscum contagiosum, parapoxvirus) | |
| Infecciones por parásitos (escabiosis) | |
| Infección por micobacterias | |
| Neoplasias | Deciduosis cutánea (endometriosis) |
| Carcinoma embrionario | |
| Tumores mesenquimales (leiomiomas, rabdomiosarcomas) | |
| Linfadenoma cutáneo | |
| Blastos CD30+ en los centros germinales de linfomas primarios cutáneos de células B |
Modificada de Kempf et al3.
En cuanto a los infiltrados linfoides CD30+ en la pitiriasis liquenoides et varioliformis acuta, aunque en ocasiones aparece monoclonalidad en las células T, estas son habitualmente CD8+ y pueden ser intraepidérmicas, hechos que permiten el diagnóstico diferencial con la PL.
Historia de la clasificación de los síndromes linfoproliferativos CD30+Tras el descubrimiento en 1982 de Ki-12, y la observación posterior de que las células tumorales anaplásicas de los casos de PL y LACG marcaban CD30+, a mediados de la década de los ochenta se reconocieron los linfomas CD30+ como entidades independientes, aunque aún no se distinguía entre LACG cutáneo primario y LACG ganglionar (sistémico) y, además, este grupo no incluía la PL. En 19894,5 se describió la asociación entre la traslocación t(2;5)(p23;q35) y los LACG sistémicos. Posteriormente, se escindieron de este grupo aquellos linfomas primariamente cutáneos, con morfología superponible a las formas sistémicas pero con mejor pronóstico y sin traslocación.
La clasificación de linfomas cutáneos primarios de la European Organization for Research and Treatment of Cancer (EORTC) de 19976 reconoce por primera vez los SLP CD30+ que afectan a la piel como una entidad en sí misma. En la clasificación actual de consenso del 20057, WHO/EORTC consideran PL y LCGA y aquellos casos borderline dentro del apartado de SLP CD30+.
Una vez que los linfomas CD30+ están encuadrados en una clasificación surge el debate sobre si los términos “pleomórfico” (células de distintas formas y tamaños) y “anaplásico” (células de gran tamaño que generalmente son consideradas neoplásicas) pueden ser utilizados indistintamente para definir las células CD30+. En la anterior clasificación de la EORTC6 el epígrafe “Linfomas de células T grandes CD30+” englobaba linfomas compuestos por una celularidad pleomórfica, anaplásica o inmunoblástica con positividad para CD30 en al menos el 75% de las células tumorales. No se consideró la morfología celular como un factor pronóstico. De hecho, en una serie de 219 pacientes con procesos linfoproliferativos CD30+ no se encontraron diferencias en términos de supervivencia entre pacientes con LACG CD30+ primario cutáneo con células de morfología anaplásica y aquellos con células CD30+ no claramente anaplásicas8. Sí se evidenció, en la misma serie, una mayor tendencia a la remisión espontánea en aquellos casos de LACG CD30+ primario cutáneo histológicamente cercanos a la PL, con pocas células CD30+, frente a los linfomas con extensos infiltrados de células CD30+, independientemente de su morfología.
Síndromes linfoproliferativos CD30+La tabla 2 recoge la clasificación actual de consenso WHO-EORTC de los linfomas cutáneos primarios7. Los SLP CD30+ son el segundo grupo más frecuente de linfomas cutáneos de células T (LCCT), constituyendo hasta el 25% de estos, después de los llamados LCCT “clásicos”, que engloban la micosis fungoide (MF) y sus variantes y el síndrome de Sézary (SS), y que suman hasta el 65% de los LCCT.
Clasificación WHO-EORTC de los linfomas cutáneos primarios
| Linfomas cutáneos de células T y células natural killer (NK) |
| Micosis fungoide (MF) |
| Variantes y subtipos de MF |
| MF foliculotropa |
| Reticulosis pagetoide |
| Piel laxa granulomatosa |
| Síndrome de Sézary (SS) |
| Linfoma/leucemia de células T del adulto |
| Síndromes linfoproliferativos CD30+ |
| Papulosis linfomatoide |
| Linfoma anaplásico de células grandes |
| Linfoma de células T paniculítico/subcutáneo |
| Linfoma de células NK/T extraganglionar, tipo nasal |
| Linfoma cutáneo primario de células T periférico, inespecífico |
| Linfoma cutáneo primario agresivo de células T CD8+ (provisional) |
| Linfoma cutáneo de células T γ/δ (provisional) |
| Linfoma cutáneo primario de células T CD4+ pleomóficas de tamaño mediano/pequeño |
| Otros linfomas cutáneos de células T periférico, no especificado |
| Linfomas cutáneos de células B |
| Linfoma cutáneo primario de células B marginal |
| Linfoma cutáneo primario del centro follicular |
| Linfoma cutáneo primario de células B grandes, tipo piernas |
| Linfoma cutáneo primario de células B grandes, otros |
| Neoplasias de precursores hematológicos |
| Neoplasia hematodérmica CD4+/CD56+ (linfoma de células NK blásticas) |
Modificada de Willemze R et al7.
Hay que entender los SLP CD30+ como un espectro clínico-patológico donde PL y LACG CD30+ se sitúan en los extremos, y en la zona central están los casos inclasificables, donde no se encuentran datos clínicos o histológicos claramente diferenciadores entre PL y LACG CD30+.
La tabla 3 recoge las características de SLP CD30+ e incluye las formas sistémicas.
Síndromes linfoproliferativos CD30+: características clinicopatológicas. Diagnóstico diferencial con Linfomas anaplásicos de células grandes sistémicos¿
| PL | LACG primario cutáneo | LACG Sistémico | |
| Clínica | Edad 45 años | Edad 60 años | Edad<30 años |
| Pápulas/ nódulos necróticos | Nódulo único o múltiples (20%) agrupados | Adenopatías Síntomas B | |
| Autolimitada | Autolimitada (40%) | Progresión | |
| Recurrente | Rara afectación extracutánea (10%) | Afectación extraganglionar: 40% (la piel es la localización más frecuente) | |
| Pronóstico | Excelente. | Favorable | Peor que LACG cutáneo |
| Asociación/Progresión a LACG, MF o EH (5–20%) | Mejor que otros linfomas de células grandes | ||
| Tratamiento | Observación | Cirugía | Radioterapia+QMT |
| MTX | Radioterapia | SGN 30 | |
| Fototerapia | MTX | 5F11 | |
| QMT | |||
| Histología | Tipo A y C: células grandes anaplásicas | Células grandes anaplásicas en dermis y tejido celular subcutáneo. | Células multinucleadas y tipo Reed-Stenberg en ganglios (paracorticales) |
| Tipo B: células pequeñas cerebriformes | Epidermis respetada | ||
| IHQ | CD30+ | CD30+ (>75%) | CD30+ (>75%) |
| CD2+, CD3+, CD4+, | CD2± CD3± CD5± | CD2+CD3± | |
| CD8− , CD25+, CD71+ | CD4+,CD8∓ | CD4+,CD8∓ | |
| CD25+, CD71+ | CD25+, CD71+ | ||
| CD7−, CD15− | CD15− | CD15− | |
| HLA-DR+ | HLA-DR+ | HLA-DR+ | |
| CLA+(100%) | CLA+(44%) | CLA±(18%) | |
| EMA− | EMA− | EMA+ | |
| TIA-1, granzima B+(70%) | TIA-1, granzima B+(frecuente) | TIA-1, granzima B+(frecuente) | |
| Bcl-2 ausente | Bcl-2+(30%) | Bcl-2+ | |
| Fascina (24%) | Fascina (64%) | Fascina (91%) | |
| CD56+ (infrecuente) | CD56+ (infrecuente, no peor pronóstico) | CD56+(frecuente, peor pronóstico) | |
| Genética | ALK ausente | ALK rara | ALK frecuente |
| Mutaciones del Receptor del TGF-β ausentes | Mutaciones del Receptor del TGF-β ausentes | Mutaciones del Receptor del TGF-β presentes | |
| JunB (sobreexpresión) | JunB (sobreexpresión, 70%) | JunB (sobreexpresión) |
ALK: kinasa del linfoma anaplásico; EH: enfermedad de Hodgkin; IHQ: inmunohistoquímica; LACG: linfoma anaplásico de células grandes; MTX: metotrexato; PL: papulosis linfomatoide. QMT: poliquimioterapia. SGN30 y 5F11: anticuerpos anti-CD30, quimérico y humanizado, respectivamente24–27.
Se define como una enfermedad crónica que evoluciona en brotes de lesiones diseminadas, autocurativas, con histología altamente sugestiva de linfoma7,9–12.
La etiopatogenia de esta entidad es desconocida. Parece que en la PL las células T reguladoras CD30+ son activadas por CD30L, que proviene de los neutrófilos y eosinófilos circundantes. Esta célula T secreta TGF-β (factor de crecimiento tumoral β), que suprime la respuesta inmune local y permite el desarrollo de la lesión de PL. Este mismo TGF-β, con el tiempo, genera apoptosis de las células CD30+, con lo que la respuesta inmune se recupera y la lesión regresa13. Se ha barajado su relación con retrovirus sin resultados concluyentes14,15.
Clínicamente es una enfermedad rara (incidencia: 0,1–0,2 casos/100.000 habitantes), que afecta primariamente a adultos con una media de edad de inicio de 45 años, aunque hay casos descritos en niños12. Es algo más frecuente en varones (varón:mujer 1,5:1). Aparecen pápulas asintomáticas, frecuentemente ulceradas, que afectan al tronco y a los miembros, autolimitadas en 3–12 semanas y que a menudo, aunque no siempre, curan dejando una lesión cicatricial superficial, varioliforme. Las lesiones son recurrentes y en un mismo paciente pueden observarse en distinto estadio evolutivo (figs. 1 y 2).
Clásicamente se distinguen tres tipos de PL desde el punto de vista histológico7,9:
- 1.
Tipo A y C: superponibles a los LACG, con células atípicas de gran tamaño, anaplásicas, de núcleo irregular, nucléolo prominente, citoplasma eosinófilo y abundante. El tipo A tiene escasas células tumorales, salpicadas o en pequeños grupos, en un escenario de células mayoritariamente inflamatorias (neutrófilos, eosinófilos, histiocitos, linfocitos de pequeño tamaño), formando un infiltrado en forma de cuña con la base dirigida a la epidermis (fig. 3). La PL tipo C se caracteriza por infiltrados más extensos de células atípicas y, en menor medida, células inflamatorias acompañantes (fig. 4). En la PL el infiltrado es dérmico (en los LACG puede llegar a la hipodermis).
- 2.
Tipo B: es infrecuente (menos del 10% de los casos) y se caracteriza por células atípicas de pequeño tamaño, de núcleo cerebriforme, en un infiltrado con marcado epidermotropismo, similar a la MF.
En un mismo paciente puede haber simultáneamente lesiones de distintos tipos histológicos16.
Las características inmunofenotípicas son12:
- 1.
Células atípicas grandes (en ocasiones multinucleadas tipo células de Reed-Stenberg): CD30+, CD3+, CD4+, CD8− (equivalentes a aquellas del LACG), CD2+, CD5+ y CD7−. También se observa expresión de HLA-DR y CD25 (receptor de IL-2) y en el 70% de los casos positividad para moléculas citotóxicas como TIA-1 y granzima B. El CD56 se expresa solo en el 10% de los casos y el CD15 es negativo.
- 2.
Células atípicas de pequeño tamaño: CD30−, CD3+, CD4+, CD8−.
En la PL se observa reordenamiento clonal del gen del receptor de la célula T (TCR) en el 60–70% de los casos. Ni la traslocación t(2;5)(p23;q35), característica de los LACG ganglionares, ni ninguna otra alteración genética específica son características.
El pronóstico de la PL es bueno. Bekkenk et al realizan el seguimiento de 118 pacientes con PL durante 77 meses, y solo un 4% de ellos desarrolla un linfoma sistémico, con una mortalidad de un 2%. En esta serie la supervivencia relacionada con la enfermedad es del 100% a los 5 años8. Por otra parte, entre un 5–20% de los casos de PL son precedidos o asocian otras formas de linfomas cutáneos, generalmente MF (fig. 5), LACG o enfermedad de Hodgkin9–12. No se conoce qué factores de riesgo están implicados en esta evolución; se ha barajado una mayor expresión de fascina3.
Por este buen pronóstico, y porque no existe tratamiento curativo, en general se acepta una actitud conservadora en el manejo de la PL, incluso con abstención terapéutica en los casos más leves. El tratamiento más efectivo es metotrexato a dosis bajas (5–20mg/semana), aunque también se reconoce la fototerapia (UVB o PUVA) como una buena alternativa terapéutica7,11.
Linfoma anaplásico de células grandes CD30+Está constituido por células de gran tamaño con morfología anaplásica, pleomórfica o inmunoblástica, con positividad para CD30 en más del 75% de la celularidad tumoral7,12. Tienen que estar descartados otros LCCT, como PL o MF, así como un LACG ganglionar con afectación cutánea secundaria7.
Clínicamente afecta a adultos en la sexta década de la vida, con una proporción entre sexos de 2–3:1 (hombres:mjueres)7,12. Se manifiesta como nódulos o tumores únicos o agrupados, localizados generalmente en los miembros y la cabeza, que son multifocales sólo en un 20% de los casos (figs. 6a y b). Pueden ulcerarse y son autolimitados en un 10–40% de los casos, aunque recurrentes. La afectación extracutánea ocurre en el 10%, casi siempre infiltrando ganglios regionales7,11.
Histológicamente la célula tumoral es la descrita en los tipos A y C de PL. Sólo en un 20–25% de los casos adopta una morfología más pleomórfica o inmunoblástica, no puramente anaplásica, o incluso se trata de células pequeñas. La citomorfología no tiene valor pronóstico11. Estas células, en su mayoría CD30+ (fig. 7), se disponen en un infiltrado difuso en la dermis, sin epidermotropismo, junto con algunos linfocitos reactivos. Las lesiones ulceradas pueden simular una PL con abundante celularidad inflamatoria acompañante7.
Desde el punto de vista del inmunofenotipo las células tumorales son células T CD4+ activadas (solo en un 5% presentan un fenotipo T CD8+), con variable pérdida de CD2, CD5 y CD3. Frecuentemente expresan proteínas citotóxicas (granzima B, TIA-1, perforina). La expresión de CD56 es rara y no entraña valor pronóstico7. A diferencia del linfoma de Hodgkin, el CD15 es negativo, y al contrario que en los linfomas sistémicos o ganglionares CD30+, los LACG primariamente cutáneos expresan el antígeno linfocitario cutáneo (CLA) y no expresan el antígeno de membrana epitelial (EMA) ni la quinasa del linfoma anaplásico (ALK), producto de la traslocación t(2;5)(p23;q35)11,12.
La mayoría de estos linfomas presentan reordenamiento monoclonal positivo para TCR (más del 90%)12.
La supervivencia supera el 90% a los 10 años, por lo que el pronóstico es bastante favorable, y generalmente no se ve enturbiado por la multiplicidad de lesiones tumorales o la afectación secundaria de ganglios regionales12. Esto contrasta con el peor pronóstico de su variante sistémica, que afecta a niños y adolescentes, y sigue un curso más agresivo con necesidad de quimioterapia17.
En cuanto al tratamiento, en las formas localizadas y lesiones únicas la radioterapia o la escisión simple constituyen la primera opción terapéutica. Para los casos con lesiones múltiples el tratamiento consiste en metotrexato a dosis bajas o radioterapia, si las lesiones están muy localizadas17. Si ya existe enfermedad ganglionar o extracutánea se debe considerar la poliquimioterapia tipo CHOP.
Otros linfomas con células CD30+ (No incluidos en el grupo de SLP CD30+)En la tabla 4 se recogen los tipos de linfomas cutáneos y de origen ganglionar que pueden presentar entre sus células tumorales algunos elementos CD30+3.
Procesos linfoproliferativos con células CD30+
| Síndromes linfoproliferativos CD30+ (Clasificación WHO/EORTC 2005) | Papulosis linfomatoide (PL) |
| Linfoma anaplásico de células grandes CD30+ (LACG) | |
| Otros | MF y síndrome de Sézary en trasformación |
| Reticulosis pagetoide | |
| Leucemia/linfoma de célula T del adulto | |
| Linfoma de Hodgkin. | |
| Linfoma cutáneo de células T angiocéntrico de la infancia (linfoma tipo hidroa) | |
| Reacciones cutáneas de células atípicas CD30+ asociadas a leucemias y linfomas |
Modificada de Kempf W et al3.
En aproximadamente la mitad de los casos de MF y SS que sufren transformación hacia linfomas de células grandes de alto grado existe presencia de células CD30+, dato que no influye en el pronóstico. En casos de MF en estadios de mancha y placa es infrecuente encontrar en la epidermis células CD30+3. El diagnóstico diferencial entre la MF/SS en trasformación y un LACG primario cutáneo sólo se puede realizar con el antecedente clínico de la presencia de manchas, placas o eritrodermia en el primer caso, ya que resulta imposible desde el punto de vista histológico o del fenotipo de las células tumorales. La transformación a célula grande en la MF18 puede aparecer en la fase de placas, pero ocurre con mayor frecuencia en estadios más avanzados (hasta el 50% de los casos en fase tumoral). Para aceptar esta transformación algunos autores exigen que las células grandes o blásticas supongan un 25% del infiltrado, y otros hasta el 50%18. Parece que el estadio y la elevación de lactato deshidrogenasa (LDH) y β2-microglobulina son factores predictivos para la transformación de una MF en un linfoma de células grandes18.
Hasta en un 50% de los casos de leucemia/linfoma de células T del adulto puede existir afectación cutánea. En estas situaciones es imprescindible la determinación del human T-lymphotropic virus (HTLV), su agente causal, para el diagnóstico diferencial, ya que clínicamente puede aparecer como pápulas, placas, nódulos, tumores o eritrodermia, e histológicamente se presenta como un infiltrado difuso de células de mediano o gran tamaño pleomórficas, con o sin epidermotropismo, de fenotipo T y con posible expresión de CD30+ muy similar a aquellas de LACG CD30+.
A diferencia de este último, la afectación cutánea en la enfermedad de Hodgkin es rara (1%) y supone un signo de mal pronóstico. Son excepcionales los casos primariamente cutáneos. Clínicamente son pápulas, placas o nódulos ulcerados, formados por la infiltración de células de Hodgkin, y hasta en la mitad de los casos células de Reed-Stenberg. Todas ellas son CD30+ y un buen porcentaje de las mismas expresan además CD15, hecho que permite establecer el diagnóstico diferencial con los SLP CD30+.
ControversiasClonalidadExiste verdadera controversia en cuanto a la clonalidad3 de las células CD30+, incluso cuando se utilizan métodos de reordenamiento extremadamente sensibles. Mientras que algunos autores19 al estudiar casos de PL defienden la monoclonalidad de las células CD30+ frente a la naturaleza policlonal de las CD30−, otros trabajos20 hallan monoclonalidad en las células de pequeño tamaño CD30− acompañantes, mientras que las células grandes CD30+ resultan policlonales. Queda abierta la pregunta de si la morfología se puede llegar a correlacionar con la clonalidad (células CD30+ grandes policlonales frente a CD30− de pequeño tamaño monoclonal).
Mientras que en no todos los casos de PL se demuestra monoclonalidad entre las células del infiltrado, la mayoría de los LACG CD30+ son claramente clonales, procediendo esta clonalidad de las células CD30+ anaplásicas de gran tamaño13. Parece que uno, o incluso más de un clon, probablemente dominantes de células CD30+ surgen de un conjunto de células T CD30+ policlonales13.
Existe una relación clonal en algunos de aquellos casos de PL que se asocian a otros linfomas (MF, enfermedad de Hodgkin o LACG cutáneo primario o sistémico); concretamente la literatura aporta hasta 22 casos13. Como posible explicación a este fenómeno Kadin et al propusieron en 1992 la hipótesis de que en todos estos casos existe un clon anómalo de células T oculto, del que derivan subclones con anomalías genéticas adquiridas que dan lugar a PL, MF o enfermedad de Hodgkin en el mismo paciente21.
Dificultades de diagnóstico: espectro de los síndromes linfoproliferativos CD30+Estas dificultades diagnósticas3 tienen dos orígenes:
- 1.
Diagnóstico diferencial entre PL y LACG primario cutáneo: el máximo exponente de dificultad es el caso de la PL tipo C. Las lesiones aisladas o múltiples limitadas a una región anatómica sugieren un LACG CD30+, mientras que las diseminadas son más características de la PL. Además, el infiltrado tumoral en los LACG suele ser más profundo, afectando al tejido celular subcutáneo. Sin embargo, con frecuencia, sólo la evolución del paciente nos dirá con certeza qué cuadro padece.
También resulta difícil el diagnóstico diferencial de PL tipo B y la MF, donde la presentación clínica (manchas, placas) es fundamental. Esto se complica en los casos recientemente descritos de MF papulosa22, sobre todo si este tipo de lesiones no se acompañan de las clásicas manchas y placas.
- 2.
Diagnóstico diferencial entre LACG CD30+ cutáneo primario y secundario: no existen diferencias clínicas o histológicas entre ambos. Los parámetros inmunohistoquímicos (ALK, EMA) y genéticos (traslocación t[2,5]) son positivos cuando la infiltración linfoide cutánea es secundaria a un LACG CD30+ ganglionar. Igualmente, la mayor expresión de bcl-2 y de fascina en los LACG sistémicos también puede ser útil. El estudio de extensión desempeña un papel importante. Además, también se puede tener en cuenta que los linfomas primariamente cutáneos, a diferencia de los secundarios, son raros en niños, no se asocian con el virus de Epstein-Barr y generalmente tienen un buen pronóstico.
En ambos grupos los estudios de reordenamiento no resultan de utilidad para establecer el diagnóstico definitivo.
Bekkenk et al8 proponen un algoritmo diagnóstico de estos SLP CD30+ que puede resultar interesante conocer (fig. 8).
Figura 8.Diagnóstico diferencial de los síndromes linfoproliferativos CD30+. Modificada de Bekkenk et al13. MF: micosis fungoide; VIH: virus de la inmunodeficiencia humana.
Destacan formas clínicas como la PL regional o localizada, la ya conocida PL folicular23 (fig. 9) o la PL pustulosa. Menos claros son los casos de PL con afectación exclusivamente mucosa (oral)3. Los autores han visto un caso de PL con un brote de lesiones en la mucosa vulvar (no publicado). Histológicamente hay formas folículo y siringotropas, asociadas o no con mucinosis folicular (de forma similar a lo que ocurre con la MF folicular). Los infiltrados celulares pueden ser angiocéntricos3.
Linfomas de células grandes anaplásicas CD30+Desde el punto de vista histológico destacan los casos con infiltración masiva de neutrófilos, que se han denominado “LACG CD30+ rico en neutrófilos”3. Clínicamente son lesiones de predominio facial, de rápido crecimiento, pustulosas, que pueden llegar a simular un pioderma gangrenoso. En ocasiones todos estos neutrófilos acompañantes pueden llegar a eclipsar a las verdaderas células tumorales.
Existe el LACG tipo queratoacantoma3, con hiperplasia pseudoepiteliomatosa sobre el infiltrado de células CD30+. También se puede encontrar hiperplasia pseudoepiteliomatosa en lesiones de PL, y esto se puede explicar por la síntesis por parte de las células CD30+ del factor de crecimiento epidérmico. Cabe mencionar una variante sarcomatosa, con abundantes células tumorales fusiformes.
Propuestas terapéuticasDesde mediados de la década de los noventa se contempla el antígeno CD30+ no sólo como un elemento diagnóstico, sino como una posible diana terapéutica para anticuerpos monoclonales, es decir, anti-CD30+1. Un punto a su favor es su mínima expresión en células normales con localización exclusiva en el tejido linfoide. Desde el punto de vista hematológico existen estudios con anticuerpos quiméricos (SGN30) y humanizados (MDX-060, 5F11) dirigidos contra CD30 para el tratamiento de LACG ganglionar, donde resultados preliminares señalan su eficacia en combinación con quimioterapia24. En el caso del SGN30 Forero et al25,26 presentaron resultados de un ensayo fase II donde se trataban 6 casos de LACG CD30+ ganglionar refractarios a otros tratamientos, durante 6 semanas (ciclos semanales). Obtuvieron respuesta en la mitad de los pacientes, con remisión completa en uno de ellos. En otro estudio más reciente se comprobó que los efectos adversos más frecuentes son leves e incluyen fiebre, astenia y náuseas27.
En una actualización reciente sobre tratamiento de LCCT, Whittaker et al26 hacen referencia a un nuevo estudio que evalúa la eficacia de este fármaco en pacientes con LACG CD30+ cutáneo y MF CD30+ en transformación. Se objetiva respuesta en 5 de 6 pacientes con una toxicidad mínima. Anteriormente Sheehan et al habían descrito un caso de LACG CD30+ cutáneo, multifocal, refractario a otros tratamientos, que fue tratado con anticuerpo monoclonal CD30+, dentro de un ensayo clínico. El paciente, tras un mes de tratamiento (ciclos semanales), permaneció en remisión completa durante al menos tres meses. Los autores matizan que es necesario un mayor tiempo de seguimiento para establecer claras conclusiones28.
ConclusiónLos SLP CD30+ son el segundo grupo más frecuente de LCCT. Su diagnóstico no siempre resulta fácil: conlleva conocer la evolución clínica, así como los patrones histológicos e inmunohistoquímicos, sobre todo para realizar el diagnóstico diferencial con otros LCCT y con linfomas sistémicos. Numerosos puntos en su diagnóstico y etiopatogenia siguen oscuros, aunque a la vez surgen nuevas propuestas terapéuticas.
Conflicto de interesesLos autores declaran no tener ningún conflicto de intereses.